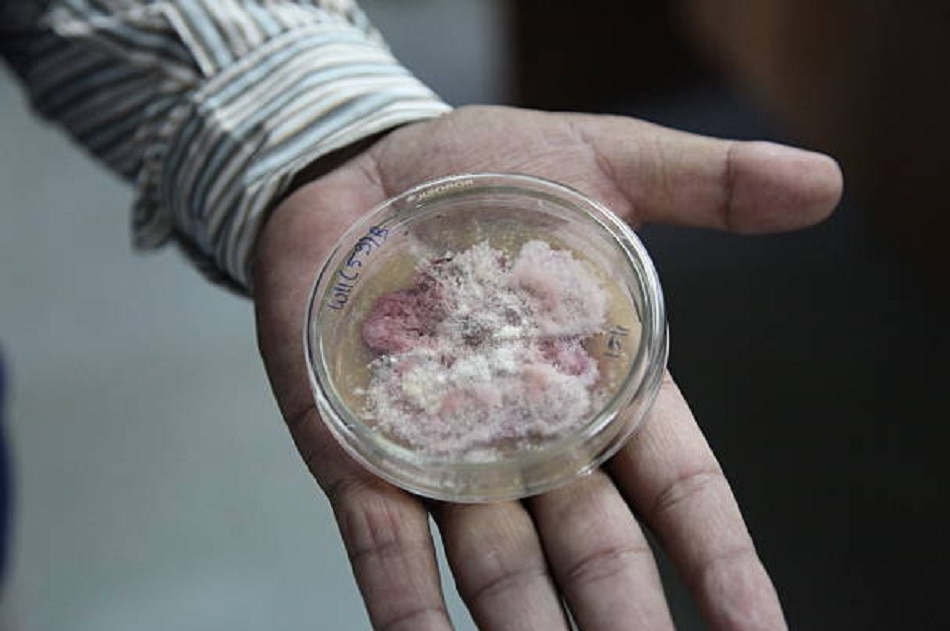
कोविड-19 से जंग में वैज्ञानिकों के नए हथियार

Corona: इंजेक्शन की जगह टैबलेट से वैक्सीन देने की तैयारी, क्या होगी बड़ी गेम चेंजर?
कोरोना वायरस के संक्रमण से बचाने के लिए लोगों को इंजेक्शन के जरिए वैक्सीन दी जा रही है. लेकिन भविष्य में टैबलेट और इनहेलर के रूप में भी लोगों को वैक्सीन मिल सकती है. बीबीसी की रिपोर्ट के मुताबिक, स्वीडन के सबसे बड़े साइंस पार्क ने इन्जेमो एंडरसन के नेतृत्व में इस पर काम करना शुरू कर दिया है. वो प्लास्टिक का एक ऐसा स्लिम इनहेलर बना रही हैं जिसका साइज माचिस के डिब्बी से भी आधा है.
Photo: Getty Images
एंडरसन और उनकी टीम को उम्मीद है कि ये छोटा सा इनहेलर कोरोना से जंग पूरी दुनिया के लिए एक मजबूत हथियार की तरह काम करेगा. इस इनहेलर के जरिए लोग वैक्सीन को एक पाउडर वर्जन में अपने घर ला सकेंगे. फर्म के सीईओ जोहन वोबोर्ग ने बताया कि ये बहुत सस्ती और आसानी से प्रोड्यूस होने वाली तकनीक है, जिसका इस्तेमाल आमतौर पर अस्थमा के मरीज करते हैं.
Photo: Getty Images
उन्होंने कहा, 'आप केवल इस पर लगी एक छोटी से प्लास्टिक स्लिप को हटाइए और ये इनहेलर एक्टिवेट हो जाएगा. इसके बाद इसे मुंह से लगाइए और सांस लीजिए. ये इनहेलर वैक्सीन नाक से लेकर फेफड़ों तक अपना असर दिखाएगी.'
Photo: Getty Images
Iconovo नाम की एक कंपनी ने स्टॉकहोम में एक इम्यूनोलॉजी रिसर्च स्टार्टअप ISR के साथ एक समझौता किया है, जिसने कोविड-19 के खिलाफ ड्राई-पाउडर वैक्सीन विकसित की है. यह कोविड-19 के वायरस प्रोटीन्स का इस्तेमाल करते हैं (फाइजर, मॉडर्ना, एस्ट्राजेनेका जैसे वैक्सीन RNA या DNA का इस्तेमाल करते हैं जो इन प्रोटीन्स के लिए कोड हैं).
Photo: Getty Images
इस वैक्सीन को 40 डिग्री तापमान में भी रखा जा सकता है. जबकि WHO द्वारा अप्रूव किसी भी लिक्विड फॉर्म वैक्सीन को स्टोर करके रखने में बड़ी मशक्कत करनी पड़ती है. इन्हें फ्रिज तक पहुंचाने से पहले कांच के किसी मजबूत जार में -70 डिग्री सेल्सियस के तापमान में रखना पड़ता है. ऐसा न होने पर इन वैक्सीन की प्रभावशीलता कम हो जाती है.
Photo: Reuters
ISR के फाउंडर और कोरोलिंका इंस्टिट्यूट में इम्यूनोलॉजी के प्रोफेसर ओला विंकिस्ट कहते हैं कि 'कोल्ड चेन' की मदद लिए बगैर वैक्सीन का आसान डिस्ट्रिब्यूशन बड़ा गेम चेंजर साबित हो सकता है. एक और खास बात ये कि इसे हेल्थकेयर प्रोवाइडर्स की मदद लिए बिना ही लोगों को दिया जा सकता है. ये वैक्सीन किसी टैबलेट की तरह हो सकती है.
Photo: Getty Images
कंपनी ने बताया कि फिलहाल वो अपनी वैक्सीन को कोविड-19 के बीटा वेरिएंट (साउथ अफ्रीकन स्ट्रेन) और अल्फा वेरिएंट (यूके स्ट्रेन) पर टेस्ट कर रही है. एक्सपर्ट का विश्वास है कि उनका ये कदम अफ्रीकी देशों में वैक्सीनेशन प्रोग्राम को गति देगा जहां फिलहाल कोई कंपनी वैक्सीन नहीं बना रही है. दूसरा, गर्म तापमान और बिजली की खराब सप्लाई से भी वैक्सीन को स्टोर करके रखना चुनौती भरा है.
Photo: Getty Images
Iconovo से करीब 10 मिनट के वॉकिंग डिस्टेंस पर एक और नए आविष्कार की तैयारी है. कैरोलिंस्का में ग्लोबल ट्रांसफॉर्मेशन फॉर हेल्थ के प्रोफेसर और 2016-2020 तक यूनिसेफ के ग्लोबल हेल्थ चीफ रह चुके स्वार्टिलिंग पीटरसन ने 'प्रॉमिसिंग टेक्नोलॉजी' के साथ इसे लेकर एक नया करार किया है.
स्वीडन की फार्मास्यूटिकल कंपनी Ziccum एक ऐसा फ्यूचर लिक्विड वैक्सीन तैयार कर रहा है जिसकी प्रभावशीलता की कोई लिमिट नहीं है. इससे विकासशील देशों में तथाकथित 'फिल एंड फिनिश' सुविधाओं को स्थापित करना आसान हो सकता है. इस तकनीक से विकासशील देश अपनी घरेलू जमीन पर ही वैक्सीन के फाइनल स्टेज को पूरा कर सकेंगे.
Photo: Reuters